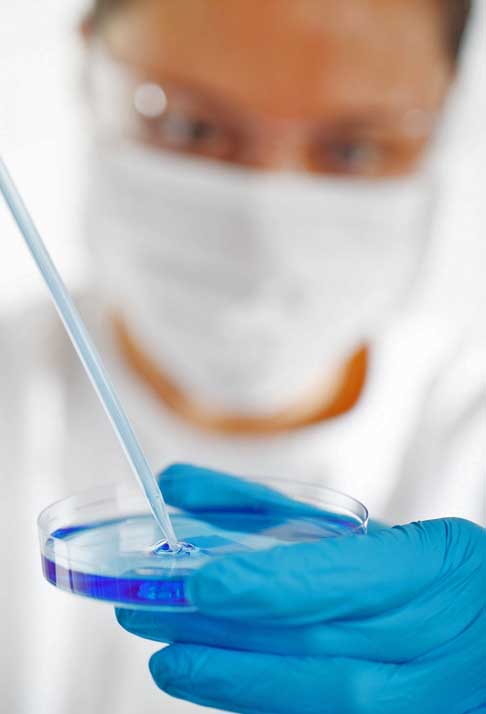
A equipe de cientistas extraiu células-tronco de embriões de macacos e injetou em embriões não relacionados da mesma espécie, o que culminou em uma gestação.

Pra quem não viu: Cientistas da China criaram animal fluorescente que viveu só 10 dias

Os cookies nos ajudam a administrar este site. Ao usar nosso site, você concorda com nosso uso de cookies. Política de privacidade
Aceitar